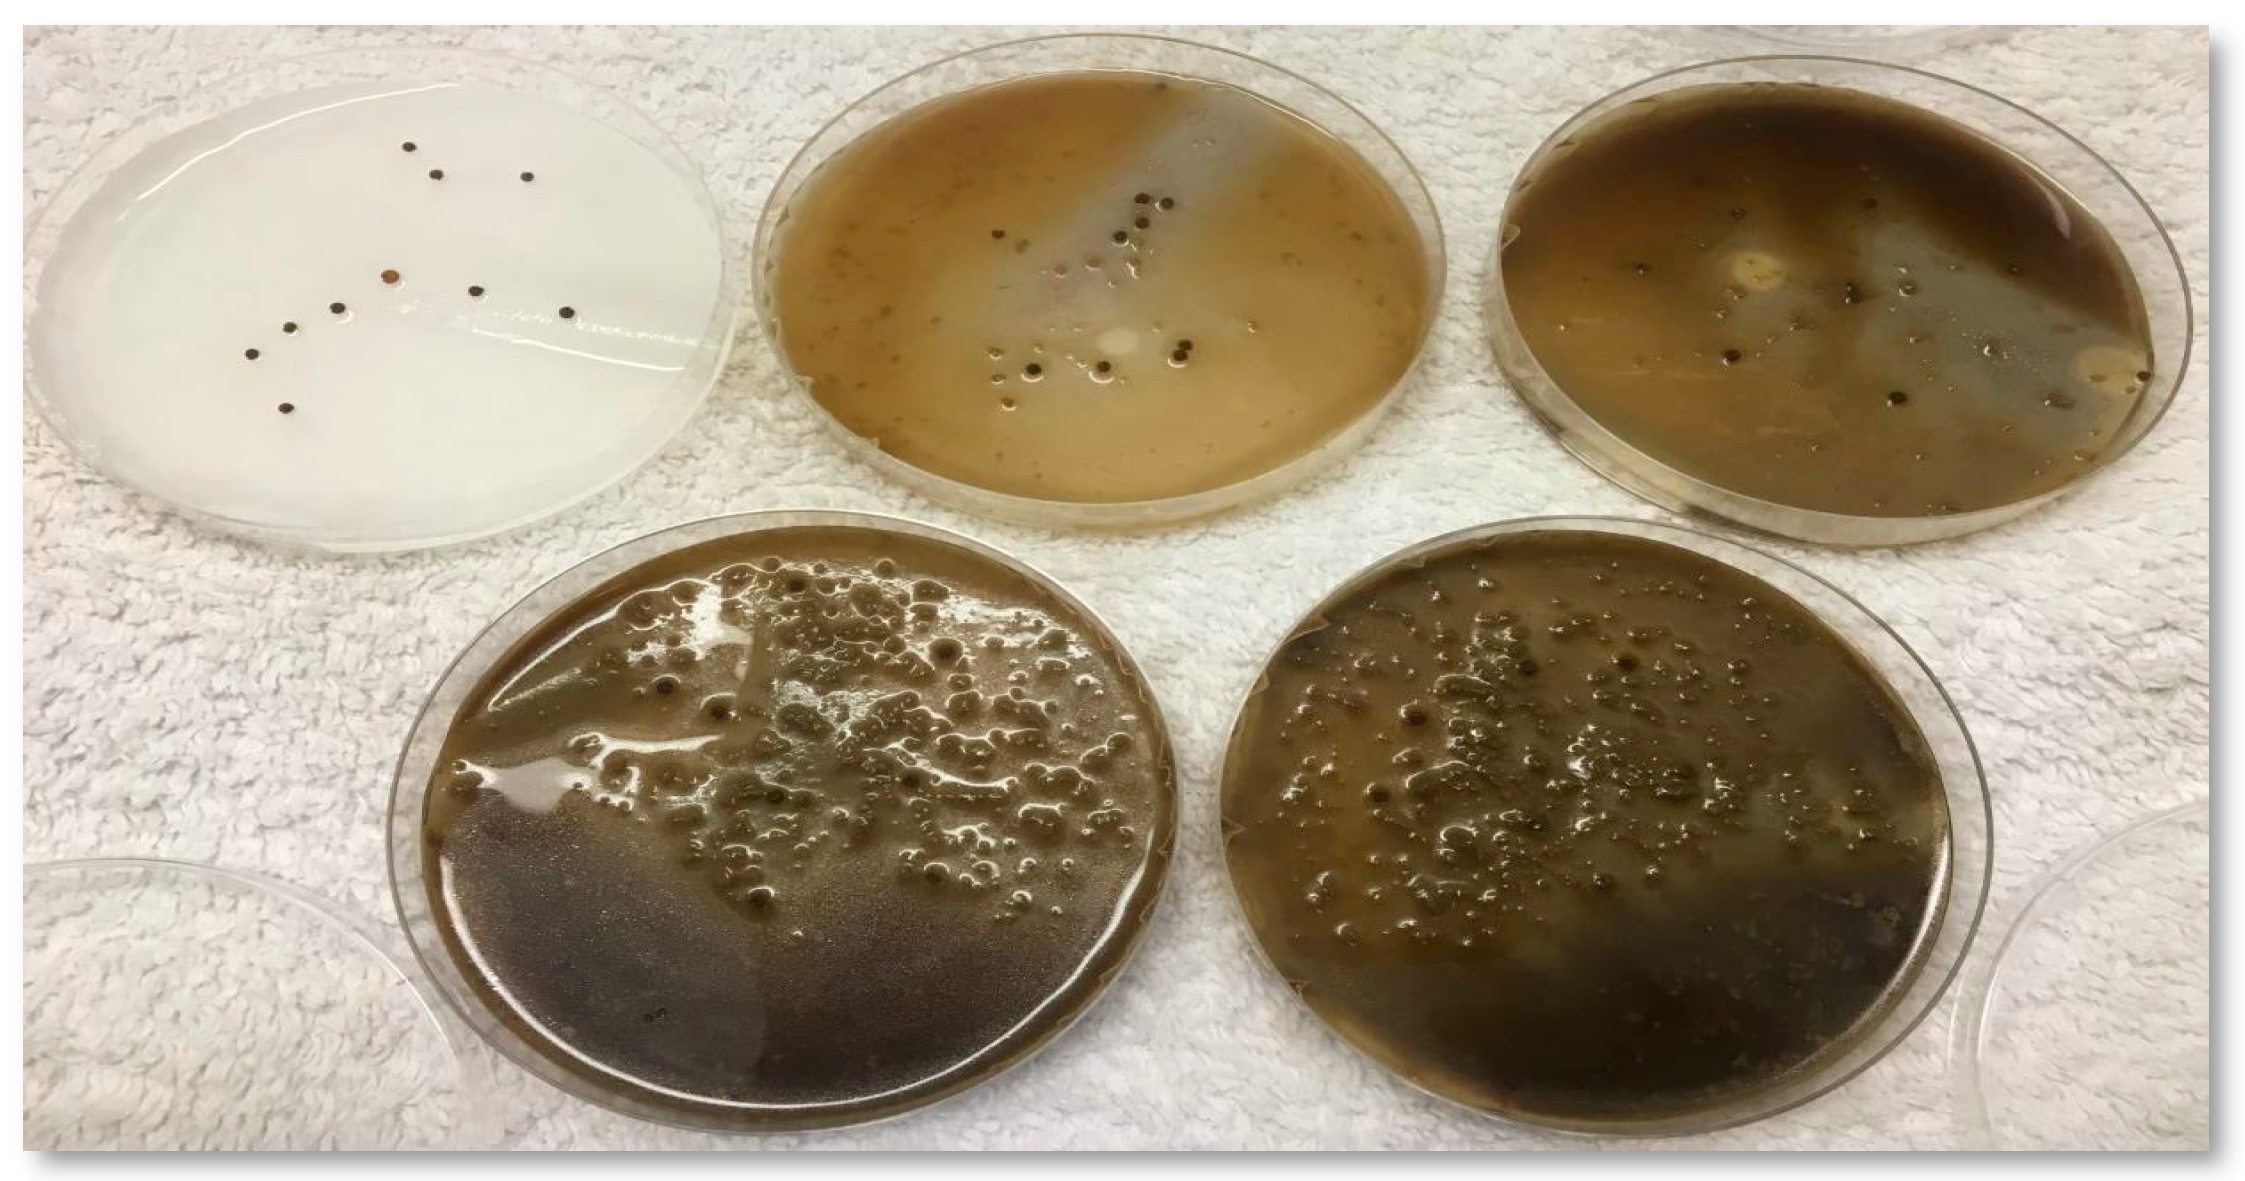
Horticulturae 05 00059 g001

Exploiting Olive Mill Byproducts and Other Waste for Organic Weed Management
Abstract
:1. Introduction
- ▪
- to evaluate the effect of OVW application on cheeseweed germination, and
- ▪
- to assess the weed suppression ability of different composts with or without OP.
2. Materials and Methods
2.1. Experiment 1: OVW Effects on Cheeseweed Germination in Petri Dishes
2.2. Experiment 2: Effect of OVW on Cheeseweed Emergence in Soil-Filled Pots
2.3. Experiment 3: Effect of Composts on Weed Pressure in Bell Peppers
2.4. Statistical Analyses
3. Results
3.1. Effect of OVW on Cheeseweed Germination in Petri Dishes
3.2. Effect of OVW on Weed Emergence in Soil-Filled Pots
3.3. Compost Pot Experiment
3.3.1. Weather information
3.3.2. Weed numbers
3.3.3. Weed dry matter production
3.3.4. Bell pepper plant health and production
4. Discussion
5. Conclusions
Author Contributions
Funding
Acknowledgments
Conflicts of Interest
References
- Wu, J.Y.; Dastgheib, F. Effects of Various Herbicides and Surfactants on Mallow (Malva spp.). In Proceedings of the 18th Asian-Pacific Weed Science Society Conference, Beijing, China, 28 May–2 June 2001; Asian-Pacific Weed Science Society: Beijing, China, 2001; pp. 589–593. [Google Scholar]
- Michael, P.J.; Steadman, K.J.; Plummer, J.A. Climatic regulation of seed dormancy and emergence of diverse Malva parviflora populations from a Mediterranean-type environment. Seed Sci. Res. 2006, 16, 273–281. [Google Scholar] [CrossRef]
- Fiorentino, A.; Gentili, A.; Isidori, M.; Monaco, P.; Nardelli, A.; Parrella, A.; Temussi, F. Environmental effects caused by olive mill wastewaters: Toxicity comparison of low-molecular-weight phenol components. J. Agric. Food. Chem. 2003, 51, 1005–1009. [Google Scholar] [CrossRef]
- Pierantozzi, P.; Zampini, C.; Torres, M.; Isla, M.I.; Verdenelli, R.A.; Meriles, J.M.; Maestri, D. Physico-chemical and toxicological assessment of liquid wastes from olive processing-related industries. J. Sci. Food Agric. 2012, 92, 216–223. [Google Scholar] [CrossRef] [PubMed]
- El-Abbassi, A.; Saadaoui, N.; Kiai, H.; Raiti, J.; Hafidi, A. Potential applications of olive mill wastewater as biopesticide for crops protection. Sci. Total Environ. 2017, 576, 10–21. [Google Scholar] [CrossRef]
- Mekki, A.; Dhouib, A.; Sayadi, S. Review: Effects of olive mill wastewater application on soil properties and plants growth. Int. J. Recycl. Org. Waste Agric. 2013, 2, 15. [Google Scholar] [CrossRef]
- Tubeileh, A.; Abdeen, M. Effect of one-time olive-mill waste water application on yield and water relations of olive trees. Acta Hortic. 2017, 303–306. [Google Scholar] [CrossRef]
- Mechri, B.; Cheheb, H.; Boussadia, O.; Attia, F.; Ben Mariem, F.; Braham, M.; Hammami, M. Effects of agronomic application of olive mill wastewater in a field of olive trees on carbohydrate profiles, chlorophyll a fluorescence and mineral nutrient content. Environ. Exp. Bot. 2011, 71, 184–191. [Google Scholar] [CrossRef]
- El Hadrami, A.; Belaqziz, M.; El Hassni, M.; Hanifi, S.; Abbad, A.; Capasso, R.; Gianfreda, L.; El Hadrami, I. Physico-chemical characterization and effects of olive oil mill wastewaters fertirrigation on the growth of some mediterranean crops. J. Agron. 2004, 3, 247–254. [Google Scholar]
- Piotrowska, A.; Iamarino, G.; Rao, M.A.; Gianfreda, L. Short-term effects of olive mill waste water (OMW) on chemical and biochemical properties of a semiarid Mediterranean soil. Soil Biol. Biochem. 2006, 38, 600–610. [Google Scholar] [CrossRef]
- Barbera, A.C.; Maucieri, C.; Cavallaro, V.; Ioppolo, A.; Spagna, G. Effects of spreading olive mill wastewater on soil properties and crops, a review. Agric. Water. Manag. 2013, 119, 43–53. [Google Scholar] [CrossRef]
- Cayuela, M.L.; Millner, P.D.; Meyer, S.L.F.; Roig, A. Potential of olive mill waste and compost as biobased pesticides against weeds, fungi, and nematodes. Sci. Total Environ. 2008, 399, 11–18. [Google Scholar] [CrossRef] [PubMed]
- Boz, O.; Dogan, M.N.; Albay, F. Olive processing wastes for weed control. Weed. Res. 2003, 43, 439–443. [Google Scholar] [CrossRef]
- Boz, O.; Ogüt, D.; Kır, K.; Doğan, M.N. Olive processing waste as a method of weed control for okra, faba bean, and onion. Weed Technol. 2009, 23, 569–573. [Google Scholar] [CrossRef]
- IBM SPSS Statistics. Version 26; IBM Corp.: Armonk, NY, USA, 2019.
- Capasso, R.; Cristinzio, G.; Evidente, A.; Scognamiglio, F. Isolation, spectroscopy and selective phytotoxic effects of polyphenols from vegetable waste waters. Phytochemical. 1992, 31, 4125–4128. [Google Scholar] [CrossRef]
- Bianco, A.; Buiarelli, F.; Cartoni, G.; Coccioli, F.; Jasionowska, R.; Margherita, P. Analysis by liquid chromatography-tandem mass spectrometry of biophenolic compounds in olives and vegetation waters, Part I. J. Sep. Sci. 2003, 26, 409–416. [Google Scholar] [CrossRef]
- Ribeiro, R.C.; Feitoza, R.B.B.; Lima, H.R.P.; De Carvalho, M.G. Phytotoxic effects of phenolic compounds on Calopogonium mucunoides (Fabaceae) roots. Aust. J. Bot. 2016, 63, 679–686. [Google Scholar] [CrossRef]
- Coleman, R.; Penner, D. Desiccant activity of short chain fatty acids. Weed Technol. 2006, 20, 410–415. [Google Scholar] [CrossRef]
- Chauhan, B.S.; Gill, G.; Preston, C. Factors affecting seed germination of little mallow (Malva parviflora) in southern Australia. Weed Sci. 2006, 54, 1045–1050. [Google Scholar] [CrossRef]
- Komilis, D.P.; Karatzas, E.; Halvadakis, C.P. The effect of olive mill wastewater on seed germination after various pretreatment techniques. J. Environ. Manag. 2005, 74, 339–348. [Google Scholar] [CrossRef]
- Mekki, A.; Dhouib, A.; Sayadi, S. Polyphenols dynamics and phytotoxicity in a soil amended by olive mill wastewaters. J. Environ. Manag. 2007, 84, 134–140. [Google Scholar] [CrossRef]
- Alburquerque, J.A.; Gonzálvez, J.; García, D.; Cegarra, J. Measuring detoxification and maturity in compost made from “alperujo”, the solid by-product of extracting olive oil by the two-phase centrifugation system. Chemosphere 2006, 64, 470–477. [Google Scholar] [CrossRef] [PubMed]
- Gómez-Muñoz, B.; Hatch, D.J.; Bol, R.; García-Ruiz, R. The Compost of Olive Mill Pomace: From a Waste to a Resource-Environmental Benefits of Its Application in Olive Oil Groves. In Sustainable Development-Authoritative and Leading Edge Content for Environmental Management; InTech Publishing: Seoul, South Korea, 2012; ISBN 978-953-51-0682-1. [Google Scholar]
- Paul, J.W.; Beauchamp, E.G. Short-term nitrogen dynamics in soil amended with fresh and composted cattle manures. Can. J. Soil Sci. 1994, 74, 147–155. [Google Scholar] [CrossRef]
- Hachicha, S.; Sallemi, F.; Medhioub, K.; Hachicha, R.; Ammar, E. Quality assessment of composts prepared with olive mill wastewater and agricultural wastes. Waste Manag. 2008, 28, 2593–2603. [Google Scholar] [CrossRef] [PubMed]
- Ait Baddi, G.; Hafidi, M.; Merlina, G.; Revel, J.C. Characterization and identification of polyphenols during composting of olive mill waste. Agrochimical 2003, 47, 161–172. [Google Scholar]

| Treatment | Description | PH | Electrical Conductivity (mS cm−1) |
|---|---|---|---|
| T1 | No OVW + 100% tap water (Control) | 7.4 | 0.66 |
| T2 | 25% OVW + 75% tap water | 5.1 | 3.39 |
| T3 | 50% OVW + 50% tap water | 5.0 | 5.48 |
| T4 | 75% OVW + 25% tap water | 4.9 | 6.65 |
| T5 | 100% OVW (as is from press, no dilution) | 4.9 | 7.23 |
| Soil PH | Organic Matter | NO3-N | Olsen P | K | Mg | Ca | S | Zn | Mn | Cu | Fe | B |
|---|---|---|---|---|---|---|---|---|---|---|---|---|
| (g kg−1) | (mg kg−1) | |||||||||||
| 7.43 | 38 | 5.48 | 15.3 | 270 | 806 | 2576 | 23.9 | 2.33 | 16.2 | 6.30 | 60.7 | 0.85 |
| Nutrient/Salt/Characteristic | CR | OP | DM | OP/DM |
|---|---|---|---|---|
| Total N (g kg−1) | 14 | 14 | 14 | 17 |
| Ammonia (mg kg−1) | 17 | <10 | 13 | 21 |
| Nitrate nitrogen (mg kg−1) | 240 | 1.2 | 430 | 15 |
| Organic N (g kg−1) | 14 | 14 | 14 | 17 |
| Phosphorus (P2O5) (g kg−1) | 8.9 | 1.2 | 13 | 9.1 |
| Total phosphorus (g kg−1) | 3.90 | 0.55 | 5.70 | 4.00 |
| Potassium (K2O) (g kg−1) | 13 | 5.40 | 17 | 14 |
| Total potassium (g kg−1) | 11 | 4.50 | 14 | 12 |
| Calcium (g kg−1) | 24 | 4.00 | 25 | 18 |
| Magnesium (g kg−1) | 6.00 | 0.50 | 16.0 | 11.0 |
| Sulfate (mg kg−1) | 2500 | 34 | 1200 | 530 |
| Copper (mg kg−1) | 71 | 9.90 | 53 | 42 |
| Zinc (mg kg−1) | 190 | 12 | 210 | 130 |
| Iron (mg kg−1) | 11,000 | 1200 | 18,000 | 11,000 |
| Manganese (mg kg−1) | 300 | 18 | 500 | 300 |
| Boron (mg kg−1) | 22 | 14 | 21 | 27 |
| Sodium (mg kg−1) | 1600 | 97 | 3300 | 1900 |
| Chloride (mg kg−1) | 3700 | 190 | 2800 | 2200 |
| pH value | 8.1 | 5.47 | 8.4 | 8.71 |
| Electrical conductivity (ds m−1) | 4.40 | 1.10 | 3.60 | 2.60 |
| Bulk Density (kg m−3) | 625 | 352 | 705 | 561 |
| Carbonates (as CaCO3) | 25 | <0.1 | 32 | 15 |
| Organic matter (g kg−1) | 359 | 930 | 307 | 476 |
| Organic carbon (g kg−1) | 170 | 490 | 150 | 280 |
| Ash (g kg−1) | 641 | 70 | 693 | 524 |
| C/N Ratio | 12.1 | 35 | 10.7 | 16.5 |
| Treatment Mix | Treatment Name |
|---|---|
| Control with no compost | Control |
| Crop residue mix 0.10 L L−1 | CR10 |
| Crop residue mix 0.20 L L−1 | CR20 |
| OP 0.10 L L−1 | OP10 |
| OP 0.20 L L−1 | OP20 |
| Dairy manure 0.10 L L−1 | DM10 |
| Dairy manure 0.20 L L−1 | DM20 |
| OP and manure 0.10 L L−1 | OP/DM10 |
| OP and manure 0.20 L L−1 | OP/DM20 |
| DAA 1 | 1 | 2 | 3 | 4 | 5 | 6 | 7 | 8 | 9 | 10 | 11 | 12 | 13 | 14 |
|---|---|---|---|---|---|---|---|---|---|---|---|---|---|---|
| P | 0.431 | 0.000 | 0.003 | 0.13 | 0.000 | 0.002 | 0.016 | 0.096 | 0.08 | 0.08 | 0.082 | 0.054 | 0.113 | 0.267 |
| Parameter | P-Value |
|---|---|
| SPAD Absorbance 13 August | 0.213 |
| SPAD Absorbance 23 August | 0.159 |
| Plant height 13 August | 0.405 |
| Plant height 23 August | 0.393 |
| Number of leaves 13 August | 0.127 |
| Number of leaves 23 August | 0.08 |
| Cumulative fruit production | 0.025 |
© 2019 by the authors. Licensee MDPI, Basel, Switzerland. This article is an open access article distributed under the terms and conditions of the Creative Commons Attribution (CC BY) license (http://creativecommons.org/licenses/by/4.0/).
Share and Cite
Tubeileh, A.M.; Schnorf, J.T.; Mondragon, I.; Gray, G.A. Exploiting Olive Mill Byproducts and Other Waste for Organic Weed Management. Horticulturae 2019, 5, 59. https://doi.org/10.3390/horticulturae5030059
Tubeileh AM, Schnorf JT, Mondragon I, Gray GA. Exploiting Olive Mill Byproducts and Other Waste for Organic Weed Management. Horticulturae. 2019; 5(3):59. https://doi.org/10.3390/horticulturae5030059
Chicago/Turabian StyleTubeileh, Ashraf M., Justin T. Schnorf, Israel Mondragon, and Gary A. Gray. 2019. "Exploiting Olive Mill Byproducts and Other Waste for Organic Weed Management" Horticulturae 5, no. 3: 59. https://doi.org/10.3390/horticulturae5030059
APA StyleTubeileh, A. M., Schnorf, J. T., Mondragon, I., & Gray, G. A. (2019). Exploiting Olive Mill Byproducts and Other Waste for Organic Weed Management. Horticulturae, 5(3), 59. https://doi.org/10.3390/horticulturae5030059

